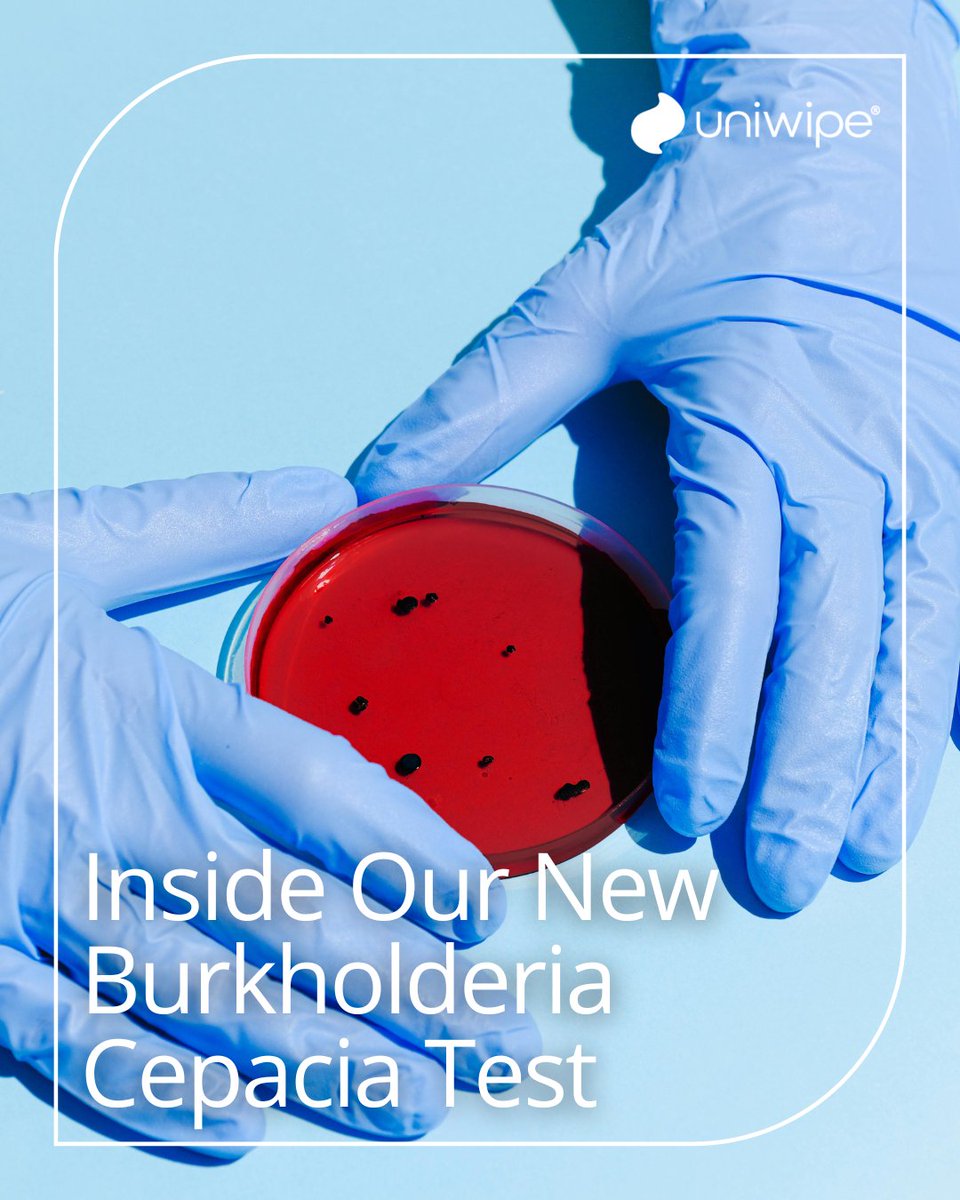
Uniwipe tweet media

Understanding kill claims, contact times, and EN testing standards is key to effective infection prevention in healthcare.
Learn more in our latest blog: uniwipe.com/understanding-…

English
Uniwipe
389 posts

@Uniwipe
Leading UK manufacturer with an immediate supply of high-quality cleaning solutions designed for infection prevention. Check out our trade wipe @UltragrimeEU